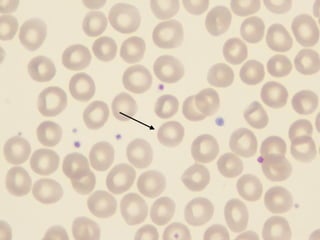
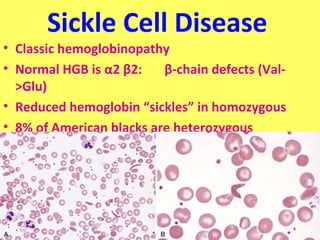
Sickle Cell Disease 
• Classic hemoglobinopathy 
• Normal HGB is α2 β2: β-chain defects (Val- 
>Glu) 
• Reduced hemoglobin “sickles” in homozygous 
• 8% of American blacks are heterozygous

This document provides an overview of red blood cell and bleeding disorders. It discusses normal red blood cell physiology as well as various anemias including those caused by blood loss, decreased production, and increased destruction. Bleeding disorders discussed include those related to platelets, clotting factors, and vessel wall abnormalities. Specific conditions covered in detail include iron deficiency anemia, sickle cell disease, thalassemias, megaloblastic anemias, aplastic anemia, immune hemolytic anemia, hereditary spherocytosis, thrombotic thrombocytopenic purpura, and von Willebrand disease. Reference ranges for red blood cell measurements are also provided.